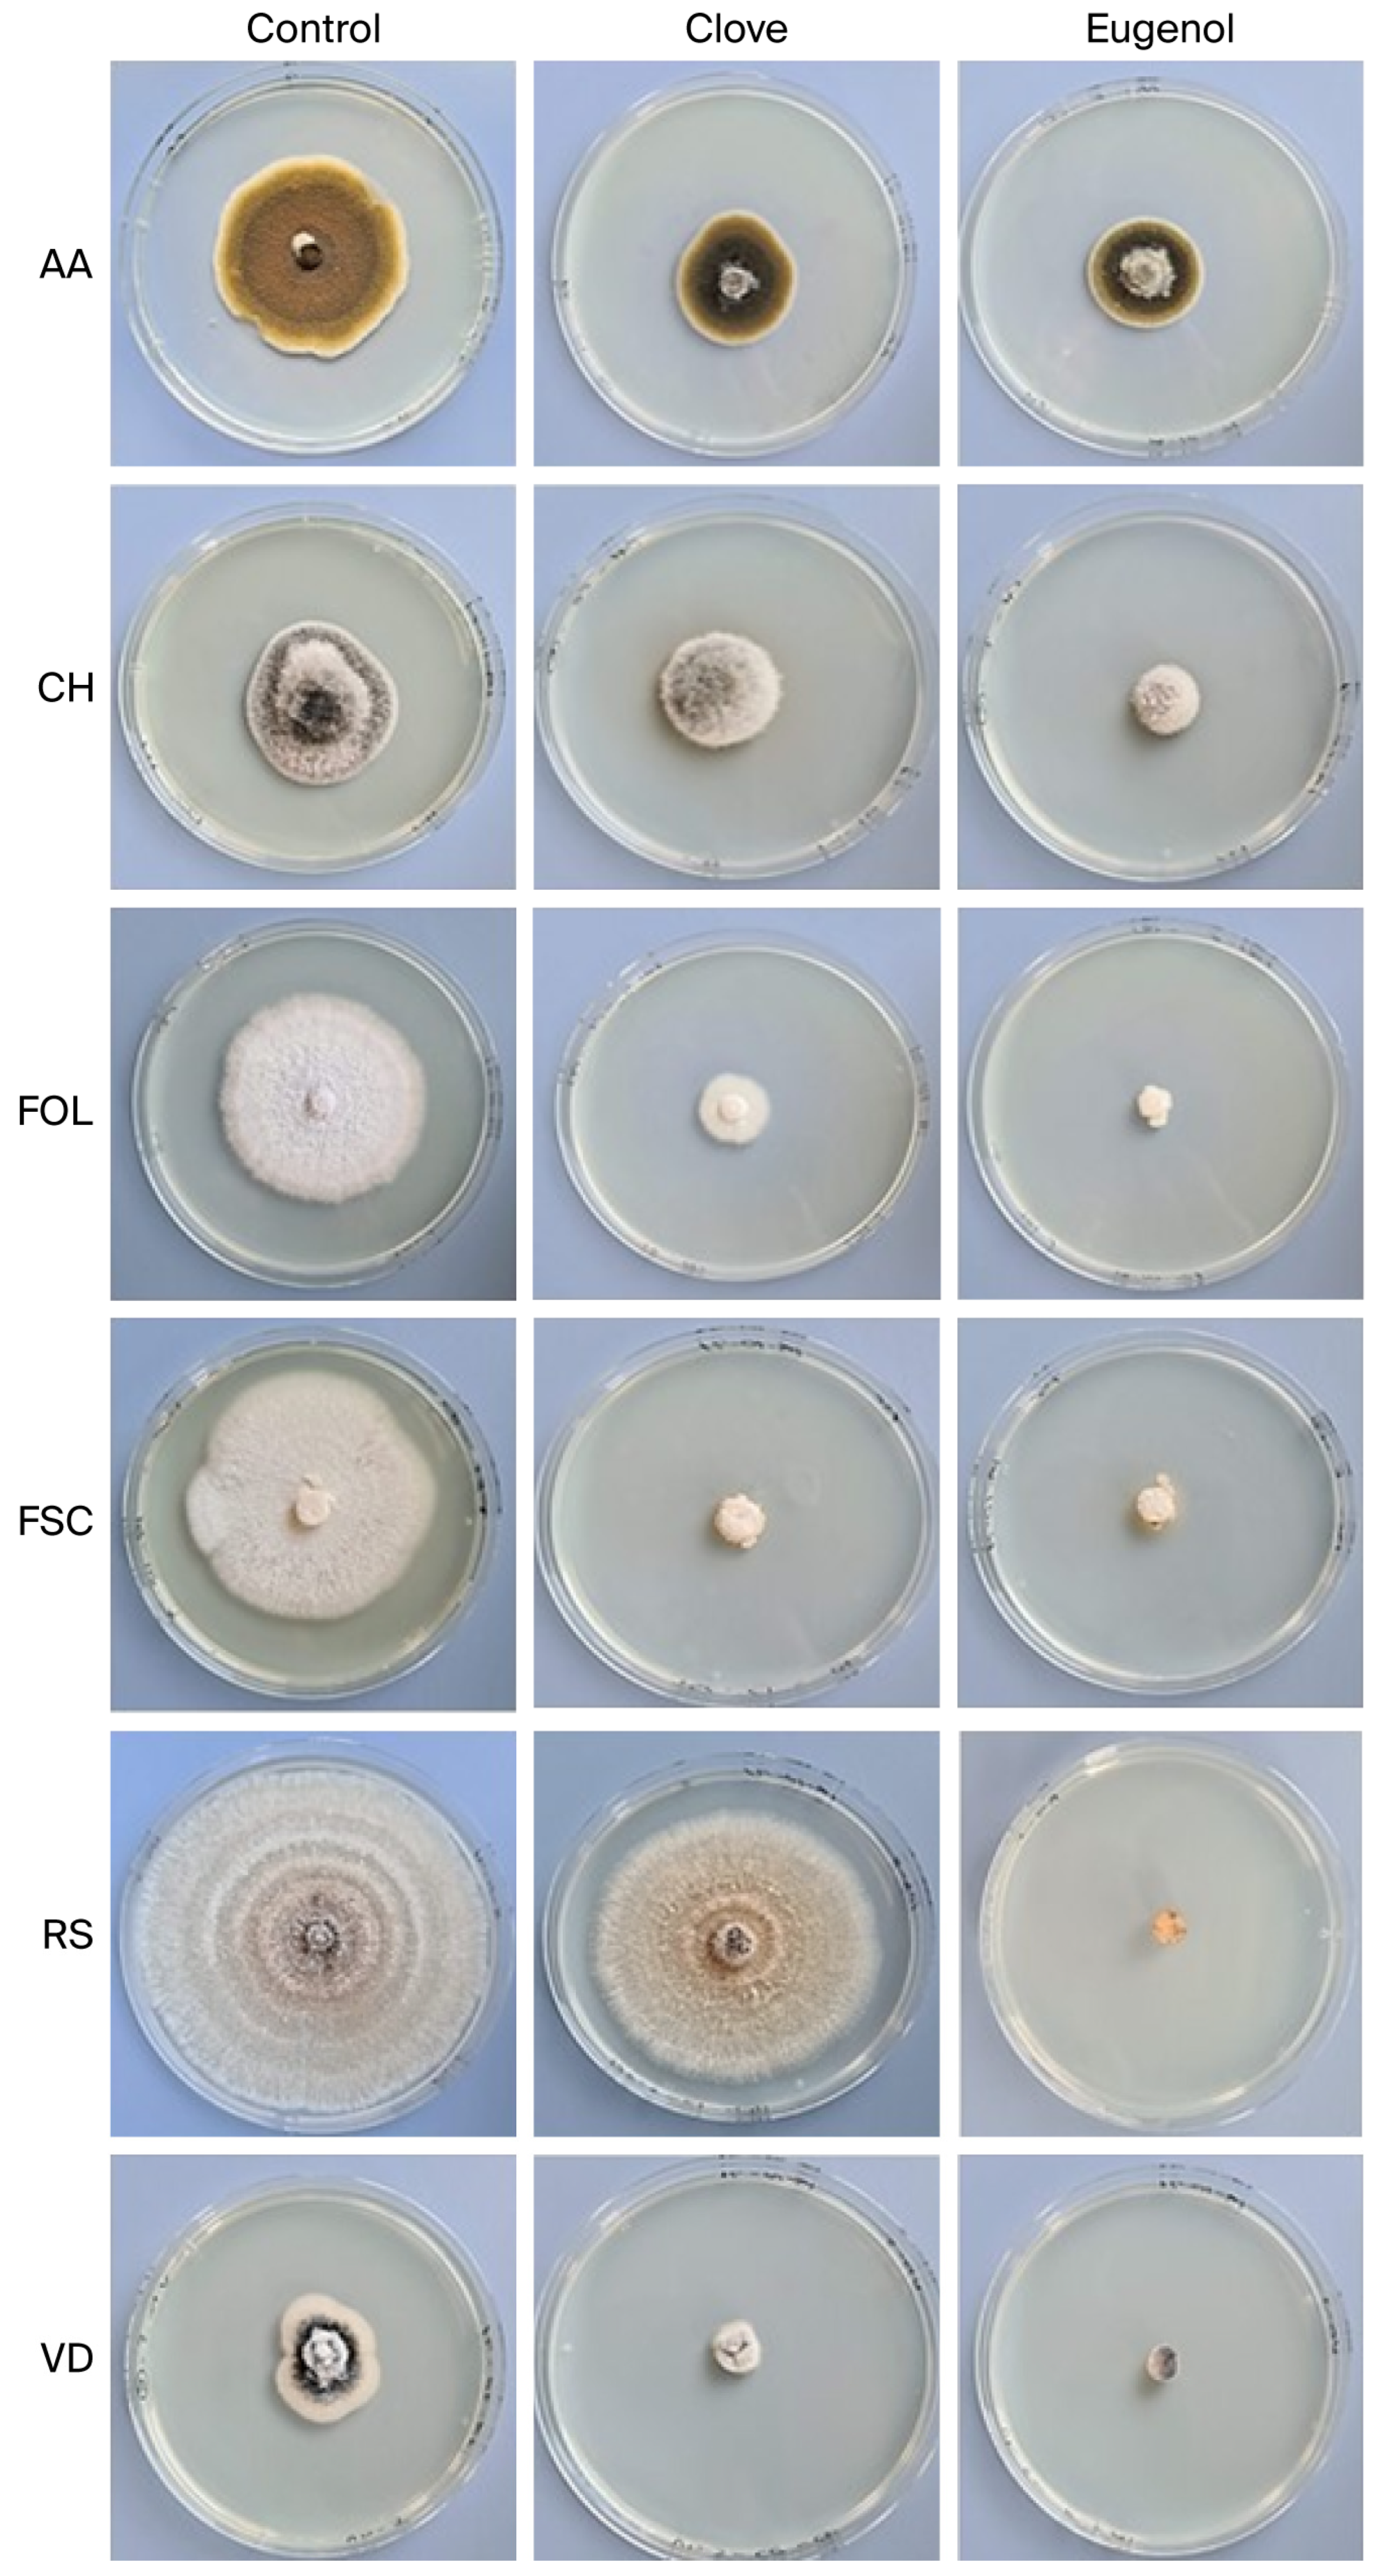
Ijms 26 09603 g003

Clove Essential Oil and Eugenol as Natural Antifungal Agents to Reduce Postharvest Losses in Melon (Cucumis melo)
Abstract
1. Introduction
2. Results
2.1. Chemical Composition of Clove Essential Oil (EO)
2.2. Antifungal Activity of the Syzygium aromaticum EO and Eugenol
2.2.1. Effect of Clove EO and Eugenol on Fungal Growth Rates
2.2.2. Determination of Mycelial Growth Inhibition (MGI) of Clove EO and Pure Eugenol on Fungal Assay
2.3. In Vivo Studies on the Melon C. melo cv. vedrantais and C. melo cv. makuwa for the Control of Fusarium oxysporum f. sp. lycopersici and Fusarium solani f. sp. cucurbitae
3. Discussion
4. Materials and Methods
4.1. Clove Samples and Eugenol
4.2. Gas Chromatography–Mass Spectrometry (GC/MS)
4.3. Fungal Species
4.4. Plant Material
4.5. In Vitro Antifungal Effect of Clove Essential Oil (CEO) and Eugenol
4.6. In Vivo Studies on the Melon C. melo cv. vedrantais and C. melo cv. makuwa for the Control of Fusarium oxysporum f. sp. lycopersici and Fusarium solani f. sp. cucurbitae
4.7. Statistical Analysis
5. Conclusions
Author Contributions
Funding
Institutional Review Board Statement
Informed Consent Statement
Data Availability Statement
Acknowledgments
Conflicts of Interest
Abbreviations
| AA | Alternaria alternata |
| CECT | Colección Española de Cultivos Tipo |
| CCM | Cucumis melo subsp. agrestis var. makuwa cultivar makuwa |
| CCV | Cucumis melo subsp. melo var. cantalupensis cultivar vedrantais |
| Cl | Clove essential oil |
| CH | Curvularia hawaiiensis |
| DON | Deoxynivalenol |
| GC/MS | Gas Chromatography–Mass Spectrometry |
| E | Pure eugenol |
| EO | Essential oil |
| FOL | Fusarium oxysporum f. sp. lycopersici |
| FSC | Fusarium solani f. sp. cucurbitae |
| FIESC | Fusarium incarnatum–equiseti species complex |
| FSSC | Fusarium solani species complex |
| GIHF | Grupo de Investigación en Hongos Fitopatógenos, Instituto Agroforestal de Mediterráneo of the Universitat Politècnica de València |
| MGI | Mycelial growth inhibition |
| NIST | National Institute of Standards and Technology |
| PDA | Potato dextrose agar |
| RIs | Retention indices |
| RS | Rhizoctonia solani |
| VD | Verticillium dahliae |
References
- Chomicki, G.; Schaefer, H.; Renner, S.S. Origin and domestication of Cucurbitaceae crops: Insights from phylogenies, genomics and archaeology. New Phytol. 2019, 5, 1240–1255. [Google Scholar] [CrossRef]
- Wasylikowa, K.; van der Veen, M. An archaeobotanical contribution to the history of watermelon, Citrullus lanatus (Thunb.) Matsum. & Nakai (syn. C. vulgaris Schrad.). Veg. Hist. Archaeobot. 2004, 13, 213–217. [Google Scholar] [CrossRef]
- Olarewaju, O.O.; Fajinmi, O.O.; Arthur, G.D.; Coopoosamy, R.M.; Naidoo, K.K. Food and medicinal relevance of Cucurbitaceae species in Eastern and Southern Africa. Bull. Natl. Res. Cent. 2021, 45, 208. [Google Scholar] [CrossRef]
- Murkute, S.P.; Paulbuhe, S.S.; Kathar, N.P.; Sanap, G.S.; Tambe, J.D. Review on introduction of Cucurbitaceae family, short classification and salient pharmacological features of Momordica charantia. Int. J. Curr. Sci. (IJCSPUB) 2022, 12, 695–704. [Google Scholar] [CrossRef]
- Namet, S.; Khan, M.R.; Aadil, R.M.; Zia, M.A. Development and stabilization of value-added functional drink using melon by-product agricultural waste. J. Food Process. Preserv. 2023, 2023, 6631784. [Google Scholar] [CrossRef]
- Neuza, J.; da Silva, A.C.; Veronezi, C.M. Antioxidant and pharmacological activity of Cucumis melo var. cantaloupe. In Multiple Biological Activities of Unconventional Seed Oils; Abdalbasit, A.M., Ed.; Academic Press: Cambridge, MA, USA, 2022; Chapter 13; pp. 147–170. [Google Scholar] [CrossRef]
- Uriarte, A.; Mazquiaran Bergera, L.; Rodríguez Alonso, P.; Valero Gaspar, T.; Ruiz Moreno, E.; Manuel Ávila Torres, J.; Varela Moreiras, G. Informe de Estado de Situación Sobre “Frutas y Hortalizas: Nutrición y Salud en la España del Siglo XXI” Fundación Española de la Nutrición (FEN). 2018, p. 198. Available online: https://www.fesnad.org/resources/files/Noticias/frutasYHortalizas.pdf (accessed on 10 June 2025).
- Statistical Database of Food and Agriculture Organization of the United Nations (FAOSTAT). Available online: https://www.fao.org/faostat/es/#rankings/countries_by_commodity (accessed on 10 June 2025).
- Ministerio de Agricultura, Pesca y Alimentación (MAPA); Gobierno de España. Producciones Agrícolas, Frutas y Hortalizas, Melón y Sandía, Situación Campana 2024. Available online: https://www.mapa.gob.es/es/agricultura/temas/producciones-agricolas/frutas-y-hortalizas/informacion_subsectorial (accessed on 10 May 2025).
- Ministerio de Agricultura, Pesca y Alimentación (MAPA); Gobierno de España. Superficies y Producciones de Cultivos. 2022. Available online: https://www.mapa.gob.es/es/estadistica/temas/publicaciones/anuario-de-estadistica/2022?parte=3&capitulo=7&grupo=6&seccion=21 (accessed on 10 May 2025).
- Blancard, D.; Lecoq, H.; Pitrat, M. Enfermedades de las cucurbitáceas. Observar, Identificar, Luchar; Mundi-Prensa: Madrid, Spain, 1991; p. 301. [Google Scholar]
- Medeiros Araújo, M.B.; Moreira, G.M.; Nascimento, L.V.; de Almeida Nogueira, G.; de Nascimento, S.R.; Pfenning, L.H.; de Ambrósio, M.M. Fusarium rot of melon is caused by several Fusarium species. Plant Pathol. 2020, 70, 712–721. [Google Scholar] [CrossRef]
- Seblani, R.; Keinath, A.P.; Munkvold, G. Gummy stem blight: One disease, three pathogens. Mol. Plant Pathol. 2023, 8, 825–837. [Google Scholar] [CrossRef]
- Slebi, E.A.; Al-Juboory, H.H. Biological and chemical control of melon root rot disease: A review. Arab. J. Pl. Prot. 2024, 42, 465–473. [Google Scholar] [CrossRef]
- INRAE (National Research Institute for Agriculture, Food and Environment) Ephytia. Disease and Pest Index. Melon: List of Diseases and Pests. 2025. Available online: https://ephytia.inra.fr/en/C/7629/Melon-Melon-List-of-diseases-and-pests#:~:text=%2D%20Cucumber%20mosaic%20virus%20(CMV),yellow%20mosaic%20virus%20(ZYMV)%20%2D (accessed on 10 June 2025).
- Filho, F.O.; Silva, E.O.; Lopes, M.M.A.; Ribeiro, P.R.V.; Oster, A.H.; Guedes, J.A.C.; Zampieri, D.S.; Bordallo, P.D.N.; Zocolo, G.J. Effect of pulsed light on postharvest disease control-related metabolomic variation in melon (Cucumis melo) artificially inoculated with Fusarium pallidoroseum. PLoS ONE 2020, 15, e0220097. [Google Scholar] [CrossRef] [PubMed]
- El-Khizzi, N.; Bakheshwai, S.; Parvez, S. Bipolaris: A plant pathogen causing human infections—An emerging problem in Saudi Arabia. Res. J. Microbiol. 2010, 5, 212–217. [Google Scholar] [CrossRef][Green Version]
- Vismer, H.F.; Shephard, G.S.; Rheeder, J.P.; van der Westhuizen, L.; Bandyopadhyay, R. Relative severity of fumonisin contamination of cereal crops in West Africa. Food Addit. Contam. 2015, 11, 1952–1958. [Google Scholar] [CrossRef]
- Weikl, F.; Radl, V.; Munch, J.C.; Pritsch, K. Targeting allergenic fungi in agricultural environments aids the identification of major sources and potential risks for human health. Sci. Total Environ. 2015, 529, 223–230. [Google Scholar] [CrossRef]
- Soliman, K.M.; Badeaa, R.I. Effect of oil extracted from some medicinal plants on different mycotoxigenic fungi. Food Chem. Toxicol. 2002, 40, 1669–1675. [Google Scholar] [CrossRef]
- Santamarina, M.P.; Ibañez, M.D.; Marqués, M.; Roselló, J.; Giménez, S.; Blásquez, M.A. Bioactivity of essential oils in phytopathogenic and post-harvest fungi control. Nat. Prod. Res. 2017, 31, 2675–2679. [Google Scholar] [CrossRef]
- Verdeguer, M.; Roselló, J.; Castell, V.; Llorens, J.A.; Santamarina, M.P. Cherry tomato and persimmon kaki conservation with a natural and biodegradable film. Curr. Res. Food Sci. 2020, 2, 33–40, Correction in Curr. Res. Food Sci. 2020, 3, 339–340. https://doi.org/10.1016/j.crfs.2020.02.004. [Google Scholar] [CrossRef] [PubMed]
- Giménez-Santamarina, S.; Llorens-Molina, J.A.; Sempere-Ferre, F.; Santamarina, C.; Roselló, J.; Santamarina, M.P. Chemical composition of essential oils of three Mentha species and their antifungal activity against selected phytopathogenic and post-harvest fungi. All Life 2022, 15, 64–73. [Google Scholar] [CrossRef]
- Roselló, J.; Llorens-Molina, J.A.; Larran, S.; Sempere-Ferre, F.; Santamarina, M.P. Biofilm containing the Thymus serpyllum essential oil for rice and cherry tomato conservation. Front. Plant Sci. 2024, 15, 1362569. [Google Scholar] [CrossRef]
- Santamarina, M.P.; Gimenez-Santamarina, S.; Santamarina, C.; Larran, S.; Roselló, J. Conservation of tiger nut tubers with natural biofilm formulated with Thymus zygis essential oil. Molecules 2025, 30, 436. [Google Scholar] [CrossRef] [PubMed]
- Bai, J.; Li, J.; Chen, Z.; Bai, X.; Yang, Z.; Wang, Z.; Yang, Y. Antibacterial activity and mechanism of clove essential oil against foodborne pathogens. LWT 2023, 173, 114249. [Google Scholar] [CrossRef]
- Silva, M.V.; de Lima, A.D.C.A.; Silva, M.G.; Caetano, V.F.; de Andrade, M.F.; da Silva, R.G.C.; de Moraes Filho, L.E.P.T.; de Lima Silva, I.D.; Vinhas, G.M. Clove essential oil and eugenol: A review of their significance and uses. Food Biosci. 2024, 62, 105112. [Google Scholar] [CrossRef]
- Hasheminejad, N.; Khodaiyan, F.; Safari, M. Improving the antifungal activity of clove essential oil encapsulated by chitosan nanoparticles. Food Chem. 2019, 275, 113–122. [Google Scholar] [CrossRef]
- Raveau, R.; Fontaine, J.; Lounès-Hadj Sahraoui, A. Essential Oils as Potential Alternative Biocontrol Products against Plant Pathogens and Weeds: A Review. Foods 2020, 9, 365. [Google Scholar] [CrossRef]
- Qin, Y.-L.; Zhang, S.-B.; Ding, W.-Z.; Lv, Y.-Y.; Zhai, H.-C.; Wei, S.; Ma, P.-A.; Hu, Y.-S. The effect of volatile compounds of Syzygium aromaticum flower buds against Aspergillus flavus growth on wheat grain at postharvest stage. Food Control 2023, 145, 109450. [Google Scholar] [CrossRef]
- Santamarina Siurana, M.P.; Roselló Caselles, J.; Giménez, S.; Blazquez Ferrer, M.A. Commercial Laurus nobilis L. and Syzygium aromaticum L. Men. & Perry essential oils against post-harvest phytopathogenic fungi on rice. LWT-Food Sci. Technol. 2016, 65, 325–332. [Google Scholar] [CrossRef]
- Shu, C.-K.; Chung, H.L.; Lawrence, B.M. Volatile components of pocket melon (Cucumis melo L. ssp. dudaim Naud.). J. Essent. Oil Res. 1995, 7, 179–181. [Google Scholar] [CrossRef]
- Aubert, C.; Pitrat, M. Volatile compounds in the skin and pulp of Queen Anne’s pocket melon. J. Agric. Food. Chem. 2006, 54, 8177–8182. [Google Scholar] [CrossRef]
- Valverde, M.A.F.; Sánchez-Palomo, E.; Alises, M.O.; Romero, C.C.; González-Viñas, M.A. Volatile and sensory characterization of La Mancha Trujillo melons over three consecutive harvests. Foods 2021, 10, 1683. [Google Scholar] [CrossRef]
- Perpiña, G.; Roselló, S.; Esteras, C.; Beltrán, J.; Monforte, A.J.; Cebolla-Cornejo, J.; Picó, B. Analysis of aroma-related volatile compounds affected by ‘Ginsen Makuwa’ genomic regions introgressed in ‘Vedrantais’ melon background. Sci. Hortic. 2021, 276, 109664. [Google Scholar] [CrossRef]
- Bokshi, A.I.; Morris, S.C.; McConchie, R. Environmentally-safe control of postharvest diseases of melons (Cucumis melo) by integrating heat treatment, safe chemicals, and systemic acquired resistance. N. Z. J. Crop Hortic. Sci. 2007, 35, 179–186. [Google Scholar] [CrossRef]
- Troncoso-Rojas, R.; Corral-Acosta, Y.; Sánchez-Estrada, A.; García-Estrada, R.; Aguilar-Valenzuela, A.; Ojeda-Contreras, J.; Tiznado-Hernández, M.E. Postharvest treatment of isothiocyanates to control Alternaria rot in netted melon. Phytoparasitica 2009, 37, 445–451. [Google Scholar] [CrossRef]
- Biernasiuk, A.; Baj, T.; Malm, A. Clove essential oil and its main constituent, eugenol, as potential natural antifungals against Candida spp. Alone or in combination with other antimycotics due to synergistic interactions. Molecules 2023, 28, 215. [Google Scholar] [CrossRef]
- Sharma, A.; Rajendran, S.; Srivastava, A.; Sharma, S.; Kundu, B. Antifungal activities of selected essential oils against Fusarium oxysporum f. sp. lycopersici 1322, with emphasis on Syzygium aromaticum essential oil. J. Biosci. Bioeng. 2017, 123, 308–313. [Google Scholar] [CrossRef]
- Roselló, J.; Giménez, S.; Ibáñez, M.D.; Blázquez, M.A.; Santamarina, M.P. Bomba rice conservation with natural biofilm. ACS Omega 2018, 3, 2518–2526. [Google Scholar] [CrossRef]
- Muñoz Castellanos, L.; Amaya Olivas, N.; Ayala-Soto, J.; De La, O.; Contreras, C.; Zermeño Ortega, M.; Sandoval Salas, F.; Hernández-Ochoa, L. In vitro and in vivo antifungal activity of clove (Eugenia caryophyllata) and pepper (Piper nigrum L.) essential oils and functional extracts against Fusarium oxysporum and Aspergillus niger in tomato (Solanum lycopersicum L.). Int. J. Microbiol. 2020, 2020, 1702037. [Google Scholar] [CrossRef]
- Mahdikhani, M.; Davoodi, A. Evaluation of biocontrol potential of rhizosphere antagonist bacterial on fusarium wilt and plant growth in musk melon plants. Am.-Eurasian J. Sustain. Agric. 2016, 10, 15–24. [Google Scholar]
- Hussein, H.Z. Detection of trichothecene of Fusarium solani isolates by using HPLC in melon plants. Pak. J. Biotechnol. 2017, 14, 211–213. [Google Scholar]
- Perincherry, L.; Lalak-Kańczugowska, J.; Stępień, Ł. Fusarium-produced mycotoxins in plant-pathogen interactions. Toxins 2019, 11, 664. [Google Scholar] [CrossRef]
- Kourkoutas, D.; Stephen-Elmore, J.; Mottram, D.S. Comparison of the volatile compositions and flavour properties of cantaloupe, Galia and honeydew muskmelons. Food Chem. 2006, 97, 95–102. [Google Scholar] [CrossRef]
- Pitrat, M. Melon genetic resources: Phenotypic diversity and horticultural taxonomy. In Genetics and Genomics of Cucurbitaceae; Grumet, R., Katzir, N., Garcia-Mas, J., Eds.; Springer Nature: Cham, Switzerland, 2017; Volume 20, pp. 25–59. [Google Scholar] [CrossRef]
- AI, S.; Chen, L.; Huang, J.; Li, Q.; Xie, Y. Synergistic antifungal effect of citral and eugenol against the growth of Aspergillus flavus. J. Henan Univ. Technol. Nat. Sci. Ed. 2023, 44, 59–67. [Google Scholar] [CrossRef]
- Ben Miri, Y.; Nouasri, A.; Herrera, M.; Djenane, D.; Ariño, A. Antifungal activity of menthol, eugenol and their combination against Aspergillus ochraceus and Aspergillus niger in vitro and in stored cereals. Foods 2023, 12, 2108. [Google Scholar] [CrossRef]
- Albuquerque, C.C.D.; Camara, T.R.; Mariano, R.D.L.R.; Willadino, L.; Marcelino Junior, C.; Ulisses, C. Antimicrobial action of the essential oil of Lippia gracilis Schauer. Braz. Arch. Biol. Technol. 2006, 49, 527–535. [Google Scholar] [CrossRef]

| Compound | RI * | Mean ± s. e. ** |
|---|---|---|
| Sesquiterpene hydrocarbons | 8.06 ± 0.50 | |
| β-Caryophyllene | 1420 | 6.00 ± 0.39 |
| α-Humulene | 1455 | 1.68 ± 0.09 |
| allo-Aromadendrene | 1462 | 0.03 ± 0.00 |
| γ-Muurolene | 1477 | 0.02 ± 0.00 |
| α-Muurolene | 1497 | 0.03 ± 0.00 |
| trans-Calamenene | 1522 | 0.15 ± 0.01 |
| δ-Cadinene | 1521 | 0.11 ± 0.01 |
| α-Calacorene | 1543 | 0.04 ± 0.00 |
| Oxygenated sesquiterpenes | 0.92 ± 0.05 | |
| Caryophyllene oxide | 1582 | 0.78 ± 0.04 |
| Humulene epoxide II | 1607 | 0.14 ± 0.01 |
| Aromatic compounds (C6–C3; C6–C1) | 89.48 ± 0.33 | |
| Eugenol | 1357 | 89.28 ± 0.28 |
| Dihydro Eugenol | 1372 | 0.02 ± 0.02 |
| Vanillin | 1394 | 0.09 ± 0.02 |
| Methyl Eugenol | 1407 | 0.03 ± 0.00 |
| 4-Hydroxy-3-methoxy-Cinnamaldehyde | 1728 | 0.07 ± 0.01 |
| Others | 0.54 ± 0.15 | |
| Monoacetin | 1261 | 0.02 ± 0.01 |
| Diacetin | 1270 | 0.03 ± 0.01 |
| Triacetin | 1375 | 0.49 ± 0.13 |
| Total identified | 99.54 ± 0.07 | |
| Species–Treatment | Mean * | GR |
|---|---|---|
| A. alternata-PDA | 18.53 ± 11.36 | 5.62 (0.99) |
| A. alternata-Cl | 11.14 ± 7.05 | 3.47 (0.98) |
| A. alternata-E | 9.15 ± 5.91 | 2.91 (0.98) |
| C. hawaiiensis-PDA | 9.59 ± 3.62 | 1.74 (0.95) |
| C. hawaiiensis-Cl | 5.91 ± 2.46 | 1.18 (0.94) |
| C. hawaiiensis-E | 3.14 ± 0.94 | 0.45 (0.92) |
| F. oxysporum f. sp. lycopersici-PDA | 20.50 ± 12.11 | 6.00 (0.99) |
| F. oxysporum f. sp. lycopersici-Cl | 4.52 ± 3.23 | 1.62 (0.95) |
| F. oxysporum f. sp. lycopersici-E | 0.53 ± 0.89 | 0.30 (0.08) |
| F. solani f. sp. cucurbitae-PDA | 13.92 ± 8.08 | 3.99 (0.99) |
| F. solani f. sp. cucurbitae-Cl | 1.21 ± 1.29 | 0.77 (0.78) |
| F. solani f. sp. cucurbitae-E | 0.39 ± 0.65 | 0.40 (0.23) |
| R. solani-PDA | 40.01 ± 20.85 | 10.34(0.99) |
| R. solani-Cl | 13.74 ± 11.01 | 2.44 (0.98) |
| R. solani-E | 0.00 ± 0.00 | 0.00 (0.00) |
| V. dahliae-PDA | 4.51 ± 2.89 | 1.41 (0.97) |
| V. dahliae-Cl | 0.56 ± 0.93 | 0.60 (0.36) |
| V. dahliae-E | 0.00 ± 0.00 | 0.00 (0.00) |
| Treatment | AA | CH | FOL | FSC | RS | VD |
|---|---|---|---|---|---|---|
| Control | 71.00 | 29.40 | 76.90 | 51.10 | 142.40 | 17.90 |
| Cl | 43.60 | 19.30 | 18.20 | 6.20 | 61.70 | 4.50 |
| E | 35.70 | 9.20 | 4.00 | 3.10 | 0.00 | 0.00 |
| MGI (%) | ||||||
| Cl | 38.59 | 34.35 | 76.33 | 87.87 | 56.67 | 74.86 |
| E | 49.72 | 68.71 | 94.80 | 93.93 | 100.00 | 100.00 |
| SAMPLE | FUNGUS | Point a (mm) | Point b (mm) | Point c (mm) | ||||||
|---|---|---|---|---|---|---|---|---|---|---|
| Exterior | Interior | Exterior | Interior | Exterior | Interior | |||||
| Diameter | Diameter | Depth | Diameter | Diameter | Depth | Diameter | Diameter | Depth | ||
| CMV | FOL | 15.5 ± 1.5 | 15.2 ± 1.7 | 8.7 ± 2.0 | 14.5 ± 0.8 | 14.3 ± 1.8 | 9.5 ± 3.3 | 13.8 ± 1.1 | 14.2 ± 0.8 | 11.8 ± 1.0 |
| FSC | 14.4 ± 1.2 | 14.2 ± 1.7 | 11.7 ± 1.6 | 14.7 ± 1.3 | 14.0 ± 1.9 | 12.8 ± 1.7 | 14.2 ± 0.9 | 14.5 ± 1.0 | 10.7 ± 1.2 | |
| CMM | FOL | 6.3 ± 0.5 | 3.0 ± 0.0 | 3.2 ± 0.4 | 6.2 ± 0.4 | 3.3 ± 0.5 | 3.5 ± 0.5 | 6.3 ± 0.5 | 3.3 ± 0.5 | 3.3 ± 0.5 |
| FSC | 6.0 ± 0.0 | 3.0 ± 0.0 | 3.0 ± 0.0 | 6.0 ± 0.0 | 3.0 ± 0.0 | 3.0 ± 0.0 | 6.0 ± 0.0 | 3.0 ± 0.0 | 3.0 ± 0.0 | |
Disclaimer/Publisher’s Note: The statements, opinions and data contained in all publications are solely those of the individual author(s) and contributor(s) and not of MDPI and/or the editor(s). MDPI and/or the editor(s) disclaim responsibility for any injury to people or property resulting from any ideas, methods, instructions or products referred to in the content. |
© 2025 by the authors. Licensee MDPI, Basel, Switzerland. This article is an open access article distributed under the terms and conditions of the Creative Commons Attribution (CC BY) license (https://creativecommons.org/licenses/by/4.0/).
Share and Cite
Giménez-Santamarina, S.; Torres-Pagan, N.; Larran, S.; Roselló, J.; Santamarina, M.P. Clove Essential Oil and Eugenol as Natural Antifungal Agents to Reduce Postharvest Losses in Melon (Cucumis melo). Int. J. Mol. Sci. 2025, 26, 9603. https://doi.org/10.3390/ijms26199603
Giménez-Santamarina S, Torres-Pagan N, Larran S, Roselló J, Santamarina MP. Clove Essential Oil and Eugenol as Natural Antifungal Agents to Reduce Postharvest Losses in Melon (Cucumis melo). International Journal of Molecular Sciences. 2025; 26(19):9603. https://doi.org/10.3390/ijms26199603
Chicago/Turabian StyleGiménez-Santamarina, Silvia, Natalia Torres-Pagan, Silvina Larran, Josefa Roselló, and M. Pilar Santamarina. 2025. "Clove Essential Oil and Eugenol as Natural Antifungal Agents to Reduce Postharvest Losses in Melon (Cucumis melo)" International Journal of Molecular Sciences 26, no. 19: 9603. https://doi.org/10.3390/ijms26199603
APA StyleGiménez-Santamarina, S., Torres-Pagan, N., Larran, S., Roselló, J., & Santamarina, M. P. (2025). Clove Essential Oil and Eugenol as Natural Antifungal Agents to Reduce Postharvest Losses in Melon (Cucumis melo). International Journal of Molecular Sciences, 26(19), 9603. https://doi.org/10.3390/ijms26199603

